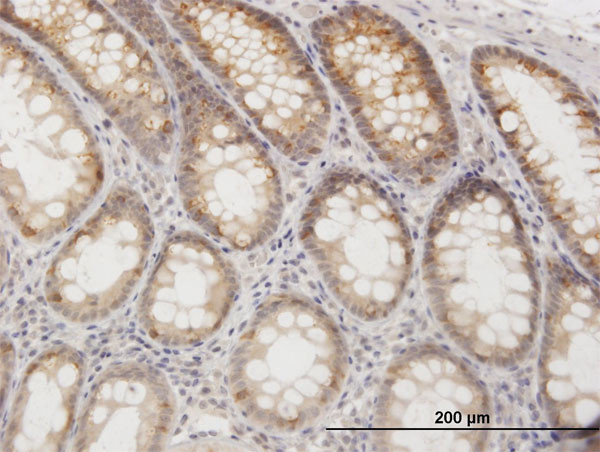
GOT1 Antibody in Immunohistochemistry (Paraffin) (IHC (P))

Search
Abnova
GOT1 Polyclonal Antibody, MaxPab™
{{$productOrderCtrl.translations['antibody.pdp.commerceCard.promotion.promotions']}}
{{$productOrderCtrl.translations['antibody.pdp.commerceCard.promotion.viewpromo']}}
{{$productOrderCtrl.translations['antibody.pdp.commerceCard.promotion.promocode']}}: {{promo.promoCode}} {{promo.promoTitle}} {{promo.promoDescription}}. {{$productOrderCtrl.translations['antibody.pdp.commerceCard.promotion.learnmore']}}
产品信息
H00002805-D01P
宿主/亚型
分类
类型
抗原
偶联物
形式
浓度
规格
保存条件
运输条件
产品详细信息
Sequence of this protein is as follows: MAPPSVFAEV PQAQPVLVFK LTADFREDPD PRKVNLGVGA YRTDDCHPWV LPVVKKVEQK IANDNSLNHE YLPILGLAEF RSCASRLALG DDSPALKEKR VGGVQSLGGT GALRIGADFL ARWYNGTNNK NTPVYVSSPT WENHNAVFSA AGFKDIRSYR YWDAEKRGLD LQGFLNDLEN APEFSIVVLH ACAHNPTGID PTPEQWKQIA SVMKHRFLFP FFDSAYQGFA SGNLERDAWA IRYFVSEGFE FFCAQSFSKN FGLYNERVGN LTVVGKEPES ILQVLSQMEK IVRITWSNPP AQGARIVAST LSNPELFEEW TGNVKTMADR ILTMRSELRA RLEALKTPGT WNHITDQIGM FSFTGLNPKQ VEYLVNEKHI YLLPSGRINV SGLTTKNLDY VATSIHEAVT KIQ
靶标信息
GOT1 is a glutamic-oxaloacetic transaminase is a pyridoxal phosphate-dependent enzyme which exists in cytoplasmic and mitochondrial forms, GOT1 and GOT2, respectively. GOT plays a role in amino acid metabolism and the urea and tricarboxylic acid cycles. The two enzymes are homodimeric and show close homology.
仅用于科研。不用于诊断过程。未经明确授权不得转售。